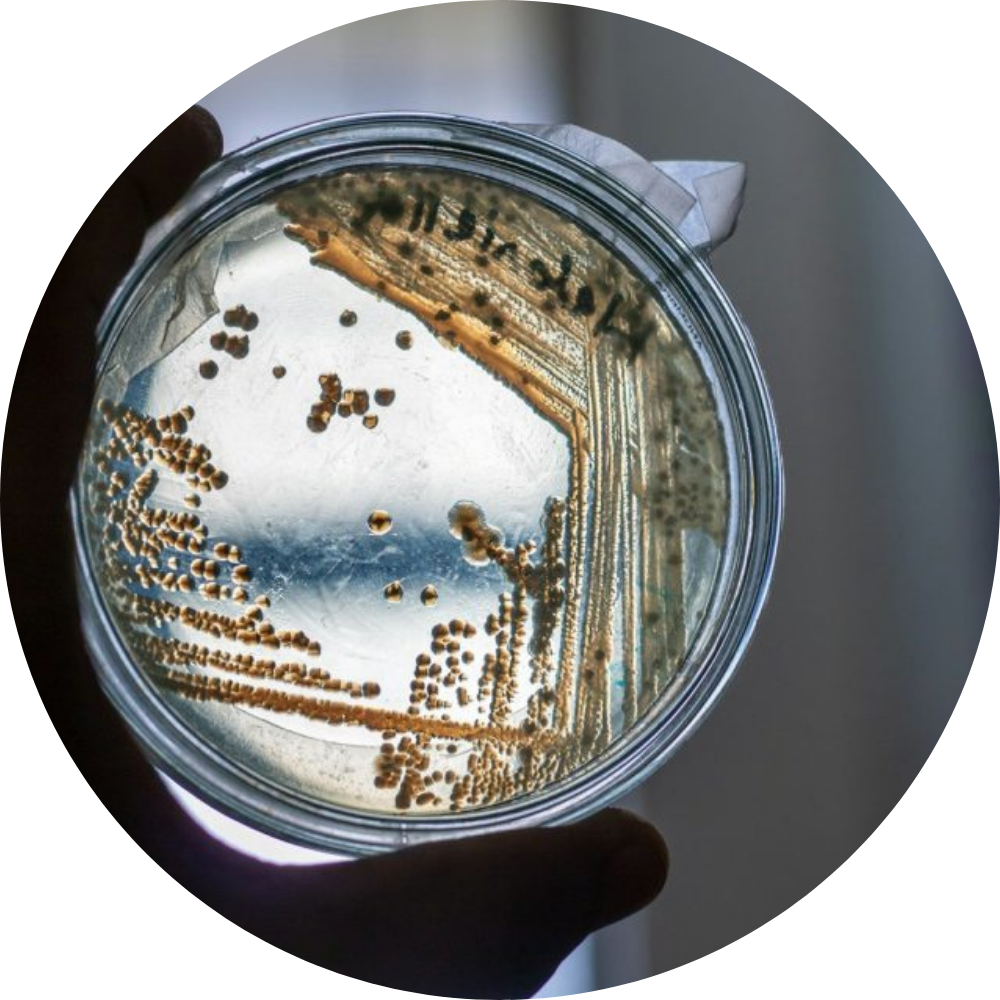
Mikrobielle Sanierung

STU Gruppe
Ihr Partner für moderne TGA‑Lösungen
Ganzheitliche Lösungen für HLSK, TGA und Bauprojekte
Willkommen bei der STU Gruppe
Die STU Grppe ist zuverlässiger und kompetenter Partner für TGA‑ und HLSK‑Planung, Bauüberwachung, Sachverständigenleistungen, Bautrocknung, Baubeheizung sowie mikrobielle Sanierung und Trinkwasserhygiene. Wir begleiten Bauherren, Architekten, Investoren und Unternehmen von der ersten Idee bis zur erfolgreichen Umsetzung – fachlich fundiert, praxisnah und lösungsorientiert.
Ob Neubau, Bestandssanierung oder akuter Schadensfall: Wir entwickeln individuelle, wirtschaftliche und nachhaltige Lösungen, die genau auf Ihr Projekt zugeschnitten sind. In Notsituationen – etwa bei Wasserschäden – reagieren wir schnell, unkompliziert und zuverlässig.

Die richtigen Ansprechpartner für Ihr Anliegen



Patrick Ulrich
Unsere Werte


Qualität
Zuverlässigkeit
Kundenzufriedenheit

Qualität
Wir legen höchsten Wert auf präzise Planung, fachgerechte Ausführung und hochwertige Ergebnisse. Von der ersten Beratung bis zur finalen Umsetzung arbeiten wir mit größter Sorgfalt und Professionalität – damit jedes Projekt unseren hohen Ansprüchen gerecht wird.

Zuverlässigkeit
Termintreue, klare Absprachen und verantwortungsvolles Handeln sind für uns selbstverständlich. Wir stehen zu unserem Wort und begleiten unsere Kunden verlässlich durch alle Phasen des Projekts – von der Anfrage bis zur Fertigstellung.

Kundenzufriedenheit
Die Bedürfnisse unserer Kunden stehen im Mittelpunkt unseres Handelns. Wir hören zu, beraten transparent und streben stets danach, Erwartungen nicht nur zu erfüllen, sondern zu übertreffen. Erst wenn Sie zufrieden sind, sind wir es auch.

Warum STU Gruppe?
Die STU Gruppe steht für fachliche Kompetenz, klare Kommunikation und eine partnerschaftliche Zusammenarbeit. Von der ersten Beratung über die Planung und Umsetzung bis hin zum erfolgreichen Projektabschluss begleiten wir unsere Kunden zuverlässig, transparent und mit einem klaren Fokus auf Qualität, Wirtschaftlichkeit und nachhaltige Lösungen.

-
Ganzheitliche Betreuung:
Planung, Überwachung, Ausführungskontrolle und Gutachten aus einer Hand
-
Erfahrene Experten:
Meisterbetriebe, zertifizierte Sachverständige und qualifizierte Fachberater
-
Praxisorientiert & unabhängig:
Objektive Bewertung und umsetzbare Lösungen
-
Zuverlässig & termintreu:
Klare Prozesse und transparente Kommunikation
-
Nachhaltig & zukunftssicher:
Energieeffiziente und hygienisch sichere Konzepte
-
Planungssicher:
Klare Konzepte sorgen für Kosten-, Termin- und Ausführungssicherheit.
Kontaktieren Sie Uns
Kontaktieren Sie uns gerne für ein unverbindliches Beratungsgespräch. Wir nehmen uns Zeit für Ihr Anliegen und entwickeln gemeinsam mit Ihnen eine fachlich fundierte, wirtschaftliche und nachhaltige Lösung für Ihr Projekt.
-
+49 155 10063778
-
info@stu-waerme.de
Unsere Leistungen auf einen Blick
Hier gibt Ihnen die STU Gruppe einen Überblick über ihre Produkte und Dienstleistungen. Sollte Ihr Anliegen nicht vollständig abgedeckt sein, stehen wir Ihnen jederzeit beratend zur Seite. Weitere Details finden Sie über die jeweiligen Buttons.

Fachplanung TGA und Bauüberwachung
Bei uns stehen Sie als Bauherr oder Architekt im Mittelpunkt. Wir möchten, dass Sie genau die passende Leistung finden. Deshalb sind umfangreiche Beratung und fachgerechte Abstimmung unser oberstes Gebot.

Sie sind sich nicht sicher, ob alles mit rechten Dingen zugeht oder möchten gegenüber Ihrem Kunden die ordnungsgemäße Ausführung der TGA Gewerke nachweisen? Dann sind Sie bei uns genau richtig.


Die Funktions- und Belegreifheizung des Estrichs steht an, oder der Winter hat Sie überrascht und es droht ein Bauverzug? Für uns kein Problem, denn: Wir heizen Ihnen ein. Ausgestattet mit verschiedensten Geräten können wir auf nahezu jede Herausforderung reagieren.

Kontaktieren Sie uns jetzt


Einblicke in Unsere Arbeiten





